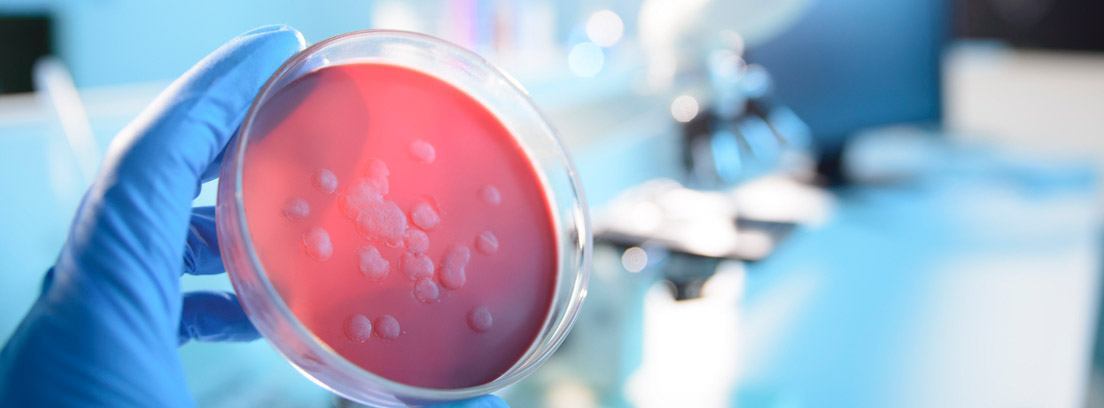
cepa laboratorio virus

Actualmente el coronavirus (COVID19) ha cogido protagonismo por el brote declarado en Wuhan (provincia de Hubei, China), el 31 de diciembre de 2019. ¿Qué es el coronavirus? ¿Estamos en riesgo de epidemia?
¿Qué son los virus denominados Coronavirus?
Los coronavirus son un tipo de virus de cadena RNA sencilla que se caracterizan por ocasionar, fundamentalmente, síntomas respiratorios en humanos. Se transmiten entre animales y personas, afectando más frecuentemente a animales. Este tipo de virus son responsables de menos del 25% de los resfriados comunes pero un mínimo cambio en su cadena genética puede ser causante de cuadros respiratorios más severos. Los coronavirus suelen provocar síntomas respiratorios graves con infiltrados neumónicos pulmonares que se pueden ver a través de una radiografía de tórax. En general, las infecciones de las vías respiratorias causadas por virus suponen un 50% del total de las infecciones respiratorias agudas.
Cuando se trata de virus normales o banales la infección suele durar pocos días y los síntomas son leves:
- Congestión nasal
- Rinitis
- Febrícula
- Mucosidad acuosa
- Estornudos
- Otitis (cuando se complica)
¿Cuáles son los síntomas del Coronavirus?
- Los síntomas más comunes incluyen:
- Tos
- Odinofagia (o dolor de garganta)
- Fiebre
- Sensación de falta de aire
En casos más graves, la infección puede causar neumonía, dificultad para respirar, fallo renal e incluso la muerte. Los casos más complicados, generalmente ocurren en personas ancianas o que padecen alguna otra enfermedad del corazón, del pulmón o problemas de inmunidad, entre otros ejemplos.
¿Cómo se contagia?
La principal forma de contagio es el contacto directo con las secreciones respiratorias de los pacientes infectados. Por ello se recomienda seguir una serie de precauciones, como el uso de mascarillas:
- Evitar el contacto con personas afectadas o que han contactado con infectados durante los primeros días
- Taparse la nariz y la boca al estornudar
- Usar pañuelos desechables
- Lavarse las manos frecuentemente
- Mantener las vías respiratorias húmedas, por ejemplo, con lavados con agua de mar o suero fisiológico
Si hemos viajado a Wuhan y, además hemos estado en contacto con un posible infectado, es imprescindible acudir a visita médica para ser valorado. Asimismo, ante cualquier síntoma, especialmente respiratorio deberá descartarse una infección. Actualmente se recomienda no viajar a China por el alto riesgo de contagio y seguir las recomendaciones de la OMS si vas a viajar.
Situación de España frente al Coronavirus
Actualmente, hay infectadas más de 80.000 personas en todo el mundo. Aunque muchos de los afectados superan sin problemas el virus, el número de fallecidos por el COVID19 ya supera los 3.000 fallecidos. En España se han detectado en las últimas semanas varios casos, tanto en la Península como en las Islas Canarias y Baleares. El total de infectados en España asciende en estos momentos a 91 personas, 89 continúan en activo mientras dos casos han sido dados de alta y han superado el virus con éxito. Las autoridades sanitarias españolas se están centrando en las últimas horas en 4 focos activos en el país que podrían ser el punto de origen de contagio (País Vasco, Málaga, Cataluña y Torrejón de Ardoz en Madrid).
¿Cómo comenzó el coronavirus COVID 19?
Cuando las autoridades sanitarias alertan de un brote, se refieren a la aparición de una epidemia en un área geográfica localizada y reducida, durante un breve periodo de tiempo. Cuando se consigue contener o el número de casos ha remitido, reduciendo el número de hospitalizados y sin que aparezcan nuevos casos, se dice que el brote ha sido controlado.
Este brote de Wuhan surgió con la aparición de una serie de personas que mostraban síntomas respiratorios que evolucionaron a una neumonía, en principio, de causa desconocida. Posteriormente, se descubrió que la mayoría de los pacientes infectados tenían en común ser trabajadores del mercado de pescado de Huanan (Wuhan) o visitantes habituales. Los epidemiólogos focalizaron su atención en el estudio y la detección del agente causal con la finalidad de identificarlo rápidamente. Para ello, se llevó a cabo un estudio de los infectados y sus contactos, lo que permitió aislar la cepa responsable comunicada oficialmente el día 9 de enero de 2019 (un nuevo coronavirus: 2019-nCoV). Ello permitió descartar otros agentes causales frecuentes, como el virus influenza de la gripe o el rinovirus.
De momento se ha procedido al cierre provisional del mercado, se ha intensificado la vigilancia en la zona y ampliado las medidas de seguimiento, así como los estudios epidemológicos, según informa la Organización Mundial de la Salud (OMS).Cuando aparece un brote o epidemia los epidemiólogos deben tomar una serie de precauciones para mantener protegida a la población y evitar que el foco se expanda:
- Aislar a los pacientes
- Identificar el foco y aislar la cepa
- Evitar la propagación del virus con medidas preventivas
- Informar a la población
Todavía hay muchas cuestiones que se desconocen
- La fuente de infección está bajo investigación y existe la posibilidad de que la fuente inicial pueda ser algún animal.
- Parece que la transmisión sería a través del contacto con secreciones respiratorias de animales infectados o secreciones respiratorias de personas (tos o estornudos de personas enfermas). Estas secreciones infectarían a otra persona si entran en contacto con su nariz, sus ojos o su boca. Como elemento tranquilizador, parece poco probable la transmisión por el aire a distancias mayores de uno o dos metros.
- Otros virus similares como SARS sólo eran transmisibles tras el inicio de la sintomatología. Pero en el caso del Coronavirus 2019 (n-CoV) no existe por el momento una evidencia suficiente al respecto, aunque hay alguna información disponible que apunta hacia ello.
Confirmada la transmisión entre humanos
El hecho de que confirme su transmisión entre humanos aumenta la presión sobre el gobierno chino para evitar una crisis de salud pública. Por eso se ha anunciado la creación de un grupo de coordinación para luchar contra este brote.
Lo que debes saber…
- El brote se originó por exposiciones en un mercado de pescado de la ciudad de Wuhan, provincia de Hubei, en China, el 31 de diciembre de 2019.
- No se ha detectado ningún caso fuera de esta ciudad pero se ha procedido al cierre del mercado, aislamiento de los afectados y ampliar la vigilancia.
- Los síntomas principales son: fiebre, disnea e infiltrados neumónicos invasivos en ambos pulmones observables en las radiografías de tórax.
Savia, la plataforma online de MAPFRE, resuelve gratis tus dudas médicas
Savia, la plataforma de servicios de salud digital de MAPFRE, pone a disposición de clientes y no clientes de la compañía, de manera gratuita, la posibilidad de chatear con los especialistas de su cuadro médico.

¿Necesitas hacerte un Test de diagnóstico para detectar Covid-19? Puedes reservar cita al precio en los mejores centros.
Regístrate en Savia la plataforma de servicios de salud digital de MAPFRE dónde podrás consultar todas tus dudas médicas por chat o videoconsulta de manera gratuita.














